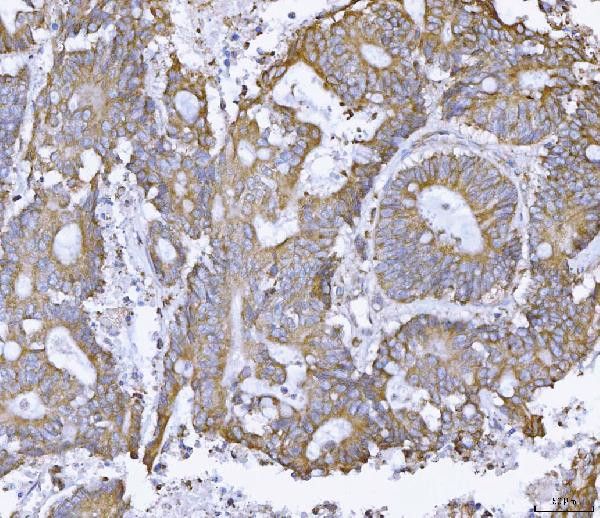
Ataxin 2 Antibody in Immunohistochemistry (Paraffin) (IHC (P))

Search
Invitrogen
Ataxin 2 Polyclonal Antibody
{{$productOrderCtrl.translations['antibody.pdp.commerceCard.promotion.promotions']}}
{{$productOrderCtrl.translations['antibody.pdp.commerceCard.promotion.viewpromo']}}
{{$productOrderCtrl.translations['antibody.pdp.commerceCard.promotion.promocode']}}: {{promo.promoCode}} {{promo.promoTitle}} {{promo.promoDescription}}. {{$productOrderCtrl.translations['antibody.pdp.commerceCard.promotion.learnmore']}}
图: 1 / 5
Ataxin 2 Antibody (PA5-78846) in IHC (P)





Please note: We are reviewing Western blot images included in the antibody testing data in our catalog, including those provided by third parties. Unless expressly labeled or annotated as “raw-unedited”, Western blot images included in the antibody testing data in our catalog may have been edited, optimized or otherwise adjusted for presentation.
产品信息
PA5-78846
种属反应
宿主/亚型
分类
类型
抗原
偶联物
形式
浓度
规格
纯化类型
保存液
内含物
保存条件
运输条件
RRID
产品详细信息
Reconstitute with 0.2 mL of distilled water to yield a concentration of 500 µg/mL.
Positive Control - WB: human Hela whole cell, human K562 whole cell, human A549 whole cell, rat brain tissue, mouse brain tissue, mouse liver tissue. IHC: human breast cancer tissue, human colonic adenoma cancer tissue, human glioma tissue, human placenta tissue.
靶标信息
The autosomal dominant cerebellar ataxias (ADCA) are a heterogeneous group of neurodegenerative disorders characterized by progressive degeneration of the cerebellum, brain stem and spinal cord. Clinically, ADCA has been divided into three groups: ADCA types I-III. Defects in this gene are the cause of spinocerebellar ataxia type 2 (SCA2). SCA2 belongs to the autosomal dominant cerebellar ataxias type I (ADCA I) which are characterized by cerebellar ataxia in combination with additional clinical features like optic atrophy, ophthalmoplegia, bulbar and extrapyramidal signs, peripheral neuropathy and dementia. SCA2 is caused by expansion of a CAG repeat in the coding region of this gene. Longer expansions result in earlier onset of the disease. Alternatively spliced transcript variants encoding different isoforms have been identified but their full length sequence has not been determined.
仅用于科研。不用于诊断过程。未经明确授权不得转售。
篇参考文献 (0)
生物信息学
蛋白别名: Ataxin-2; FLJ46772; spinocerebellar ataxia 2 (olivopontocerebellar ataxia 2, autosomal dominant, ataxin 2); spinocerebellar ataxia 2 homolog; Spinocerebellar ataxia type 2 protein; Spinocerebellar ataxia type 2 protein homolog; Trinucleotide repeat-containing gene 13 protein
基因别名: 9630045M23Rik; ATX2; ATXN2; AW544490; SCA2; TNRC13
UniProt ID: (Mouse) O70305
Entrez Gene ID: (Rat) 288663, (Mouse) 20239